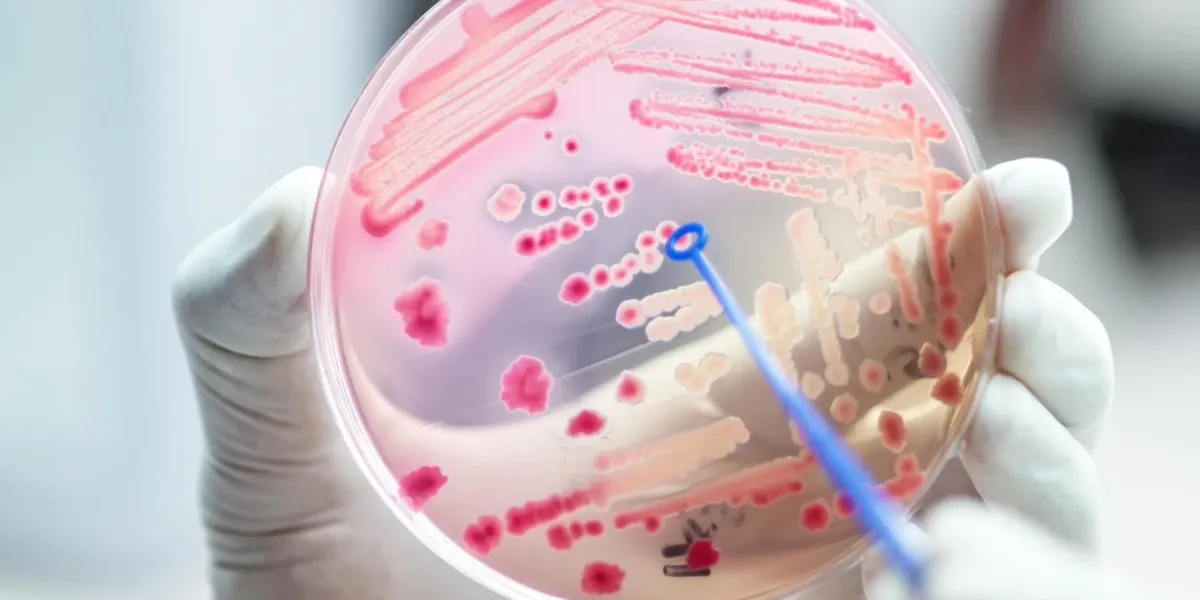
escherichai coli colonies of pink bacteria ferment lactose culture on macconkey agar in microbiology department hospital

Maladies neurologiques
Bienvenue dans notre rubrique dédiée aux maladies neurologiques. Cette section vise à fournir des informations approfondies sur les affections du système nerveux central et périphérique. Explorez nos ressources pour comprendre les causes, les symptômes, et les options de gestion des maladies neurologiques telles que la maladie d'Alzheimer, la sclérose en plaques, et d'autres conditions neurologiques. Nous sommes là pour vous accompagner dans la compréhension de ces affections complexes et pour fournir des conseils pratiques pour améliorer la qualité de vie malgré les défis neurologiques.
Image

Alzheimer et déclin cognitif
Image

Migraine
Image

Parkinson
Autres troubles neurologiques
Sclérose en plaques
Maladie de Charcot (SLA)
Image